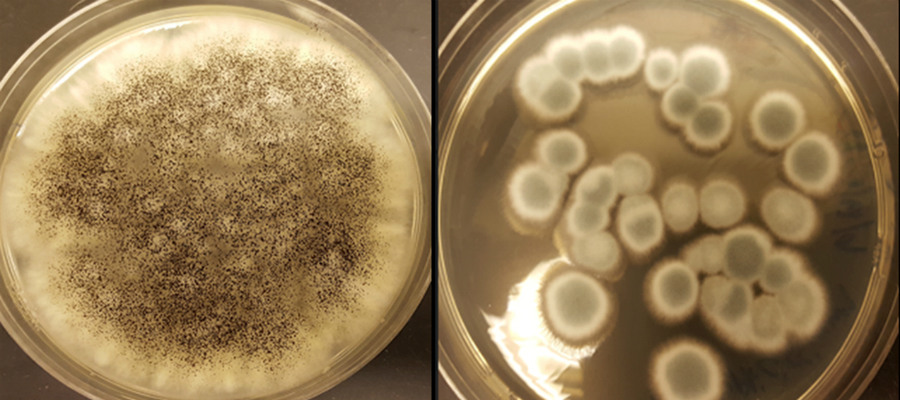

Smartphone-accu’s recyclen is duur en niet bepaald milieuvriendelijk. Schimmels die kostbare metalen uit accu’s vissen, moeten de oplossing worden.
Oplaadbare lithium-ion-accu’s in telefoons, tablets en auto’s gaan niet eeuwig mee. Vroeg of laat belanden ze op een vuilstorthoop of in een verbrandingsoven, waar ze een gevaar zijn voor het milieu. Bovendien gaan er waardevolle metalen verloren. Een team van de Universiteit van Noord-Florida heeft daar nu wat op gevonden: schimmels die de accu’s moeten gaan recyclen.
Kostbare metalen vangen
De onderzoekers namen de proef op de som door een aantal accu’s van de afvalberg te redden. Ze ontmantelden de accu’s, verpulverden de kathodes (de pluspolen van de accu’s) en stelden de resulterende pulp bloot aan drie soorten schimmels, waaronder een die voor voedselbederf zorgt.
De schimmels produceerden zuren die de kostbare metalen lithium en kobalt begonnen te ‘vangen’. Oxaalzuur en citroenzuur gaven daarbij de beste resultaten: ongeveer 85 procent van al het lithium en 48 procent van al het kobalt in de accu werd teruggewonnen.
Uit het zuur halen
Er is alleen nog een klein probleem: die waardevolle metalen uit het zuur zien te halen. Daar broeden de onderzoekers nog op. Ook hopen ze andere schimmels te testen op hun recycle-effectiviteit. In de toekomst hopen we meer te horen.
Het onderzoek wordt gepresenteerd op een bijeenkomst van de American Chemical Society.
Bronnen: American Chemical Society (ACS) via EurekAlert!, abstract wetenschappelijk artikel gepubliceerd op bijeenkomst ACS (onderaan)
Beeld: Aldo Lobos